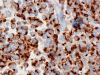
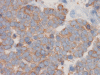

CK20
Neurofilament
Synaptophysin
| A 60 year-old Man with a
2.5 cm Mass in the Parotid Area. June, 2008, Case 806-1. Home Page |
Katerine Seywerd, M.D., Kar-Ming Fung, M.D., Ph.D. Last update: May 9, 2009.
Department of Pathology, University of Oklahoma Health Sciences Center, Oklahoma City, Oklahoma
Clinical information: Clinical information: The patient is a 60 year-old man who presented with a 2.5 cm mass in the right parotid area. The mass is non-tender. The overlying skin appears stretched by intact. A partial parotidectomy with the overlying tumor was performed and the followings are representative images.
 |
 |
 |
 |
 |
| A. | B. | C. | D. | E. |
 |
|
|
||
|
F. CK20 |
G. Neurofilament |
H. Synaptophysin |
Pathology of the case:
The mass appears to be a subcutaneous tumor that spares the dermis and epidermis (Panel A). On scanning magnification, the tumor has a infiltrative growth pattern (Panel B). Intrestingly, the tumor does not really invade into the parotid gland (Panel C). On medium magnification, the tumor cells arrange in irregular islands with a solid pattern (Panel D). On high magnification, the tumor cells have medium sized large nuclei with high nuclear to cytoplasmic ratio (Panel E) and scant amount of cytoplasm. The cytoplasmic membrane is not distinct. The nuclei have a coarse salt and pepper like pattern and without prominent nucleoli. On immunohistochemistry, strongly positive expression of CK20 in terms of dots are present in many of the tumor cells (Panel F). A similar but stronger staining pattern with antibodies against neurofilament proteins (Panel G). The tumor cells are also positive for synaptophysin (Panel H).
| DIAGNOSIS: Merkel Cell Carcinoma. |
Discussion:
General Information:
Merkel cell carcinoma (MCC) is an uncommon, highly malignant cutaneous tumor with a mortality of 33 % which is the highest of any cutaneous malignancy. It predominantly involves the head and neck area and arises in the dermis. The salient features include a small blue cell tumor type of histology with neuroendocrine immumohistochemical profile, arising in the dermis, a high rate of local recurrence, aggressive regional nodal invasion, and distant metastases.
MCC was first described by Toker in 1972 1 as “trabecular carcinoma of the skin” and since then has also been referred to as cutaneous ADUPoma, neuroendocrine carcinoma of the skin, Merkel cell tumor, primary small cell carcinoma of the skin, primary undifferentiated carcinoma of the skin and murky cell carcinoma 2. The terms Merkel cell tumor and neuroendocrine carcinoma of the skin are most commonly used, reflecting the origin and immunocytologic characteristics of such tumors. MCC has also been known to arise in the major salivary glands, in which this variant of small cell carcinoma must be distinguished from the pulmonary subtype 3, metastatic MCC 4, and metastatic small cell carcinoma and neuroendocrine carcinoma.
Epidemiologically speaking, the annual incidence in the United States is increasing and currently is 0.44 per 100,000 persons, such that roughly 1,000 new cases are seen per year 5. Although its reported rate has tripled between 1986 and 2001, MCC still remains 50-fold less common than melanoma 5. MCC occurs predominantly in Caucasians over 65 years of age, with no sex predilection. It is rare in black persons and Polynesians. Risk factors found to be associated include sun and UV light exposure, previous irradiation and exposure to radiant infrared heat. It is also believed that increasing age, immunocompromise and immunosuppression could represent additional risk factors. It has also been noted that there is a high prevalence (25 -28 %) of second neoplasms occurring before, concomitant with or after a diagnosis of MCC. Such neoplasms include squamous cell carcinoma, adenocarcinoma of the breast and ovary and hematological malignancies. 2, 5, 6
A study by Agelli an Clegg demonstrated 5 year survival rate to be 75 %, 59 % and 25 % for localized, regional and distant metastasis 7. The overall survival is associated with the stage at presentation 7. The prognosis of patients with stage 3 is poor. The average time of survival is 8 months is between diagnosis and death 4. Positive predictors of survival include female sex, younger age at diagnosis and localized disease 4, 5, 7. Local recurrences are common and occur in up to 44 % of patients 4, 5, 7. Distant metastases, which is seen in approximately one third of patients occur most commonly in the lung, chest wall or mediastinal lymph nodes.
Cell of Origin:
The most commonly accepted origin of MCC is the Merkel cell. These clear, oval cells are found in or close to the basal layer of the epidermis and function as mechanoreceptors. Both ultrastructural features (neuroendocrine granules) an immunohistochemical features (positive staining for CK 20) support the Merkel cell as the site of origin. On the other hand there are some differences which argue against this theory, including fibrous whorls and neurofilaments seen in MCC, but not in the Merkel cell. Furthermore, MCC is found in the dermis, sparing epidermal structures, whereas the Merkel cell tends to be located in the basal layer of the epidermis. Mitoses are also not seen in Merkel cells. An intermediate position also exists in which the origin of MCC is thought to be linked to an immature totipotent stem cell, which assumes neuroendocrine characteristics during malignant transformation.
Molecular Pathology:
Genetic studies have documented numerous chromosomal irregularities. Involvement of chromosome 1, 6, 7, 11, and 13 7, 8, 9 have been reported. Genetic aberrations include complete or partial trisomy and lost of chromosome. Silent mutations in KIT (exon 17) and PDGFRA (exon 10, 12 and 18) were also described but no activating mutations were identified 10.
Pathology:
Macroscopically, MCCs are typicalaly 2 to 4 cm firm, non-tender, dome-shaped red, violaceous or purple nodule located on sun exposed regions of the body. The overlying skin is usually smooth, shiny and can exhibit ulcerative, acneiform or telangiectatic features. In greater than 50 % of cases it will involve the head and neck, the extremities in 40 % and the trunk in less than 10 %. The rapidity of growth may be the only feature suggesting malignancy. It often behaves like a melanoma, with an orderly progression of lymph node involvement, allowing lymphoscintigraphy to be utilized in localizing sentinel lymph nodes.
Histologically, MCC is a dermal based tumor. Histological features often typify that of small, round blue cell tumors. The cells have very high nuclear cytpplasmic ratio, hyperchromatic nuclei with evenly distributed chromatin without prominent nucleoli. Mitotic figures are common. The tumor is characteristically separated from the epidermis by a "grenz" zone. It can be morpholgoically classified into three subtypes, namely the small cell type, the trabecular type and the intermediate type.
The small cell type have features of a small blue turmor with scant cytoplasm and small to medium sized nuclei with salt and pepper chromatin. There are numerous mitosis and scattered pyknotic nuclei. This tumor often expands into the subcutaneous tissue. The small cell type is similar to small cell tumors found at other sites. It also arises in the dermis as solid sheets and cells clusters. The clinical behavior tends to mirror that of small cell tumors of other origin. The least common subtype is the trabecular type, in which the cells are arranged into organoid clusters and trabeculae with ribbons. It often occurs adjacent to adnexal structures. The cells tend to contain more cytoplasm. The intermediate subtype is most frequently seen. It has a solid and diffuse growth pattern. Cells are less compact and contain less cytoplasm than the trabecular subtype and they usually arise adjacent to adnexa, although it can invade the epidermis. Typically they are mitotically active and necrosis is not uncommon. It has a more aggressive clinical behavior than the trabecular subtype.
MCC has a reputation of being able to demonstrate diversified differentiation and it can occur in continuity with adjacent squamous cell carcinoma and basal cell carcinoma.
Due to neuroendocrine differentiation, MCC always stain positively for neuron specific enolase (NSE), which is a general neuroendocrine tumor marker. Additionally, MCC also has positive immunoreactions for chromogranin A and synaptophysin. CD 56 (neural cell adhesion molecule or NCAM) has been shown to be positive in both pulmonary neuroendocrine cells and MCC 11. They are usually negative for vimentin. Liu et al, demonstrated MAP-2 (microtubule associated protein) expression in all samples, even though CK 20 was negative, demonstrating the sensitivity and specificity of MAP-2 as a neuroendocrine marker 12.
MCC carcinoma expresses low-molecular weight cytokeratins, (keratins 8,18,19 and 20) with cytokeratin 20 being most useful and important in diagnosis 3-10, 13. The characteristic staining pattern is that of a paranuclear dotlike pattern. It has been demonstrated that CK 20 is useful to distinguish MCC from pulmonary small cell carcinoma 13. It is considered both sensitive and specific for MCC since it is not expressed in neuroendocrine carcinomas at other sites, such as small cell lung carcinoma. Up to 30 % of metastatic neuroendocrine carcinomas of the lung may also stain for CK-20, but they can be distinguished based on their positive staining of thyroid transcription factor 1 (TTF-1), which is negative in MCC and positive in pulmonary small cell carcinoma 13. MCC are negative for S100 and Melan A/Mart-1 which helps to differentiate them from malignant melanoma. In addition, MCC are usually negative for vimentin but malignant melanomas are usually strongly positive for vimentin.
Electron microscopy would demonstrate neuroendocrine granules similar to those found in normal Merkel cells. An aggregation of intermediate filaments in a paranuclear location and the existence of many membrane-bound dense core granules are the most commonly seen ultrastructural features.
With the help of immunohistochemistry, fine needle aspiration can provide a definitive diagnosis. The cytological features, using a Romanowsky type of stain, are remarkable for paranuclear intracytoplasmic “buttons”. With the use of immunocytochemical studies these can be demonstrated to contain both cytokeratin and neurofilaments. Other cytological features include sparse cytoplasm with uniform, monotonous medium sized and abundant mitosis.
References:
Toker C. Trabecular carcinoma of the skin. A question of title. Am J Dermatopathol. 1982 4:497-500.
Nguyen BD, McCullough AE. Imaging of Merkel Cell Carcinoma. Education Exhibit, Department of Diagnostic Radiology and Laboratory Medicine and Pathology, Mayo Clinic 2002 22:367-376.
Nagao T, Gaffey TA, Olsen KD, Serizawa H, Lewis JE. Small Cell Carcinoma of the Major Salivary Glands: Clinicopathological Study With Emphasis on Cytokeratin 20 Immunoreactivity and Clinical Outcome. Am J Surg Pathol 2004 28:762-770.
Gherardi G, Marveggio C, Stiglich F.. Parotid metastasis of Merkel cell carcinoma in a young patient with ectodermal dysplasia. Diagnosis by fine needle aspiration cytology and immunocytochemistry. Acta Cytol 1990 34:831-6.
Heath ML and Nghiem P. Merkel Cell Carcinoma: If No Breslow, Then What? J Surg Oncol 2007.
Koljonen V. Merkel cell carcinoma. World J Surg Oncol. 2006 8;4:7.
Gancberg D, Feoli F, Hamels J, de Saint-Aubain N, André J, Rouas G, Verhest A, Larsimont D. Trisomy 6 in Merkel cell carcinoma: a recurrent chromosomal aberration. Histopathology. 2000 37:445-51.
Leonard JH, Leonard P, Kearsley JH. Chromosomes 1, 11, and 13 are frequently involved in karyotypic abnormalities in metastatic Merkel cell carcinoma. Cancer Genet Cytogenet. 1993 67:65-70.
Sandbrink F, Müller L, Fiebig HH, Kovacs G. Short communication: deletion 7q, trisomy 6 and 11 in a case of Merkel-cell carcinoma. Cancer Genet Cytogenet. 1988 33:305-9.
Kartha RV, Sundram UN. Silent mutations in KIT and PDGFRA and co-expression of receptors with SCF and PDGFA in Merkel cell carcinoma: implications for tyrosine kinase-based tumorigenesis. Mod Pathol 2008 21:96-104.
Bryson GJ, Lear D, Williamson R, Wong RC. Detection of the CD56+/CD45- immunophenotype by flow cytometry in neuroendocrine malignancies. J Clin Pathol 2002 55:535-537.
Liu Y, Mangini J, Saad R, Silverman AR, Abell E, Tung MY, Graner SR, Silverman JF. Diagnostic value of microtubule-associated protein-2 in Merkel cell carcinoma. Appl Immunohistochem Mol Morphol. 200311:326-9.
Cheuk W, Kwan MY, Suster S, Chan JK. Immunostaining for Thyroid Transcription Factor 1 and Cytokeratin 20 Aids the Distinction of Small Cell Carcinoma From Merkel Cell Carcinoma, But Not Pulmonary From Extrapulmonary Small Cell Carcinomas. Arch Pathol and Labora Med 2001 125:228-231.
Nagao T, Sugano I, Ishida Y, Tajima Y, Munakata S, Asoh A, Yamazaki K, Muto H, Konno A, Kondo Y, Nagao K. Primary Large-Cell Neuroendocrine Carcinoma of the Parotid Gland: Immunohistchemical and Molecular Analysis of Two Cases. Mod Pathol 2000 13:554-561.